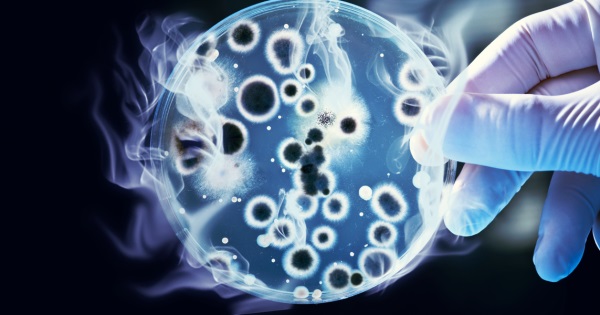

新的基因工程细菌可以协助对抗全球暖化

把温室气体转换成有用的形式(像是甲烷),需要花很多的时间。现在,一组研究人员设计出一种细菌,在仅仅单独一个自然发生的酵素步骤,能够加速这个过程。

固氮酶入门课
从’稀薄空气做出’燃料的探索,正在华盛顿大学进行。
发表于美国国家科学院院刊(Proceedings of the National Academy of Sciences)的一项最新研究,研究人员设计出一种细菌,藉由使用一种名为"固氮酶(nitrogenase)"的酵素当作催化剂,在只有单一酵素步骤,能够加速转变二氧化碳成为甲烷的过程。
这个酶并不完全是一个在实验室里创造出来的催化剂,因为它会发生在自然界里。固氮酶确实会在它的自然状态下帮助细菌。根据科学人杂志(Scientific American),“以一种称为氮还原(nitrogen reduction)或固氮作用(nitrogen fixation)的过程,把大气中的惰性氮气转变成易引起化学反应的氨气(ammonia)。”
华盛顿大学微生物教授Caroline Harwood(发表文的共同作者),被这个酶所执行的"不寻常的困难化学反应"能力,激起了好奇心。她和研究小组开始测试,是否能够改变这个酶的行为方式,让它与其它基质(substrate)反应,来产生其他有用的形式。

它如何运作
如同科学人杂志解释这个过程,这个R. palustris细菌,也被修改来增加设计过的固氮酶的生产程度。就如同在自然的化学反应里,酶需要阳光来注入燃料,以产生完成化学反应所需的能量。这些结果是相当有希望的。还有,从二氧化碳到甲烷的过程,很接近氮气到氨气自然过程的效率。Harwood说:“一般的酶,对每一个氨气(分子)做出大约两个氢原子。改变后的酶,对每一个甲烷分子做出一千个氢原子。”
许多科学家甚至把它列入考虑,积极地期待更多的研究。这项发现只是一个起点,使用固氮酶的能力来了解生物系统如何能在只有一个酵素步骤,安排资源来产生一个富含能量的碳氢化合物。

发表你的评论吧返回顶部
!评论内容需包含中文
